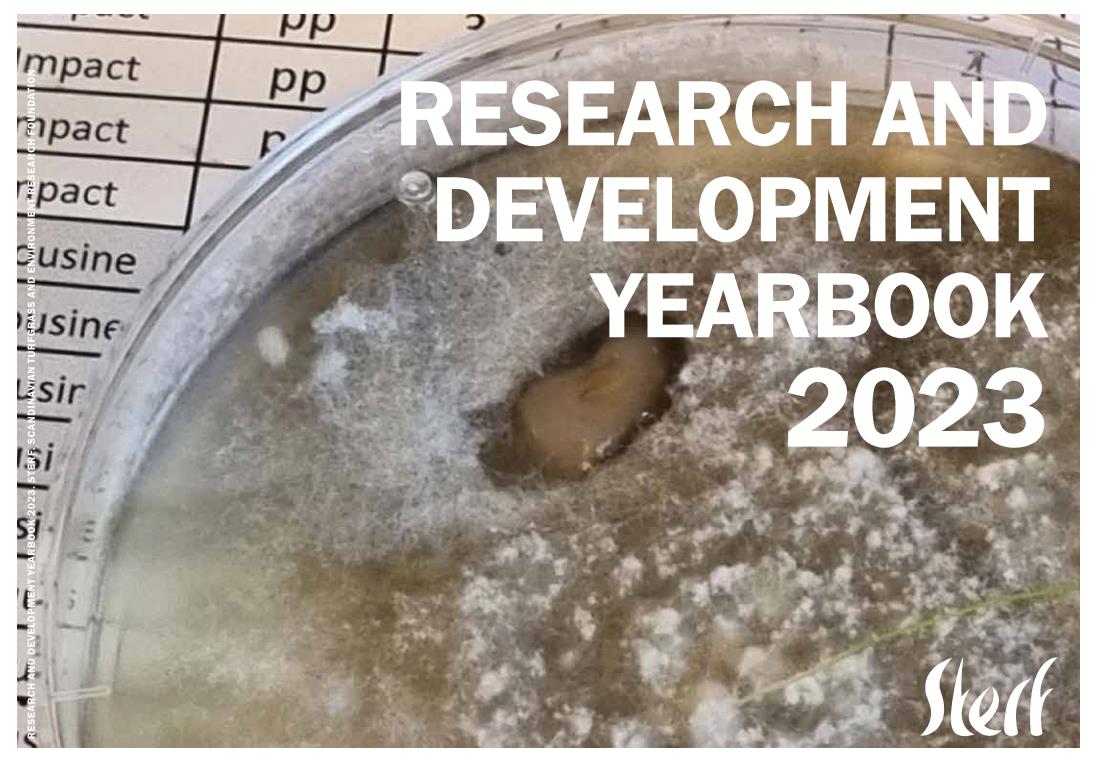

Anbei finden Sie das STERF-Jahrbuch 2023, das Ihnen einen Überblick über alle laufenden Aktivitäten und Projekte von STERF gibt.
STERF hat im Jahr 2023 ein produktives Jahr hinter sich. Erwähnenswert ist die große Anzahl von populären Artikeln, Faktenblättern, Handbüchern, Videos usw., die wir im Jahr 2023 veröffentlicht haben, insgesamt 90 Publikationen. Im Jahr 2023 organisierte STERF zwei wichtige internationale Seminare; das gemeinsame STERF- und R&A-Symposium „Nachhaltiges Golfplatzmanagement – Integriertes Rasenmanagement“ und das Abschlussseminar für ein weiteres Großprojekt, ICE-BREAKER. Als Vermächtnis der ITRC2022 ergriff STERF die Initiative und lud The R&A und die USGA ein, an derGlobal Turfgrass Research Initiative mitzuarbeiten.Im Jahr 2023 hat STERF fünf neue Projekte initiiert, um sicherzustellen, dass wir über das Wissen verfügen, das wir benötigen, um nachhaltige Golf- und Sportplätze zu bauen und zu unterhalten und gleichzeitig globale Herausforderungen zu meistern.
Das Jahrbuch finden Sie auf der temporären STERF-Website www.sterf.org
© Copyright 2023 Greenkeeper Verband Deutschland e. V.